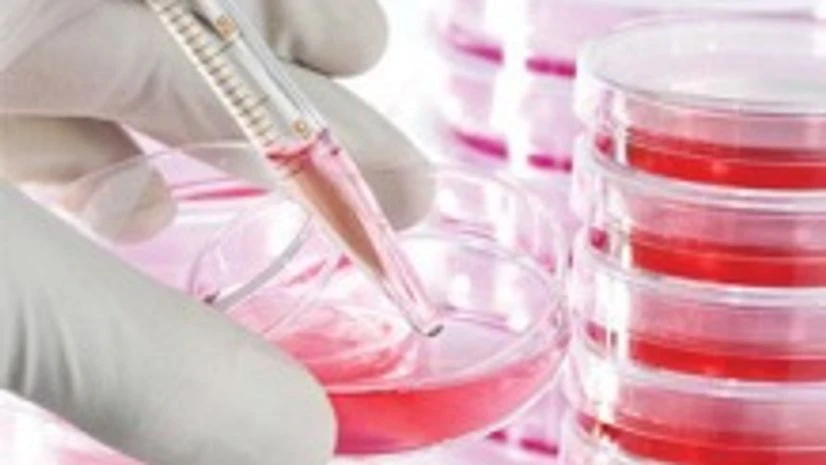
Centre to form committee to address pharmaceutical industry issues Centre to form committee to address pharmaceutical industry issues

The Centre has decided to form an inter-ministerial coordination committee to address various issues faced by the pharma industry and to ensure the growth of around Rs 2 lakh-crore sector.
The committee will be headed by Department of Pharmaceuticals Secretary V K Subburaj, and will have representatives from as many as 10 other departments or bodies.
"Pharmaceutical companies can approach this committee for whatever policy issues they are facing. They will be given immediate attention and all the issues can be addressed by this committee," Subburaj told PTI.
Also Read
"It has been decided to constitute an Inter-Ministerial Coordination Committee as recommended by the 'Task Force on Enabling Private Sector to lead the Growth of Pharmaceutical Industry'," Department of Pharmaceuticals said in a note.
The committee may also invite other government agencies/officials or representatives of industry and their associations to the meeting for more effective resolution of the pending issues.
Other members of the committee include representatives from various departments like department of industrial policy and promotion, commerce, science and technology, bio-technology, environment, health and family welfare and revenue.
Besides these, the committee will also have representatives from drug price regulator NPPA (National Pharmaceutical Pricing Authority) and Central Pollution Control Board. The Drug Controller General of India will also be a member of the committee.
Earlier, the task force in its report had suggested that the Department of Pharmaceuticals may come up with seed capital and facilitate funding with other financial institutions for the medium and small scale players in the pharmaceuticals industry.
)
